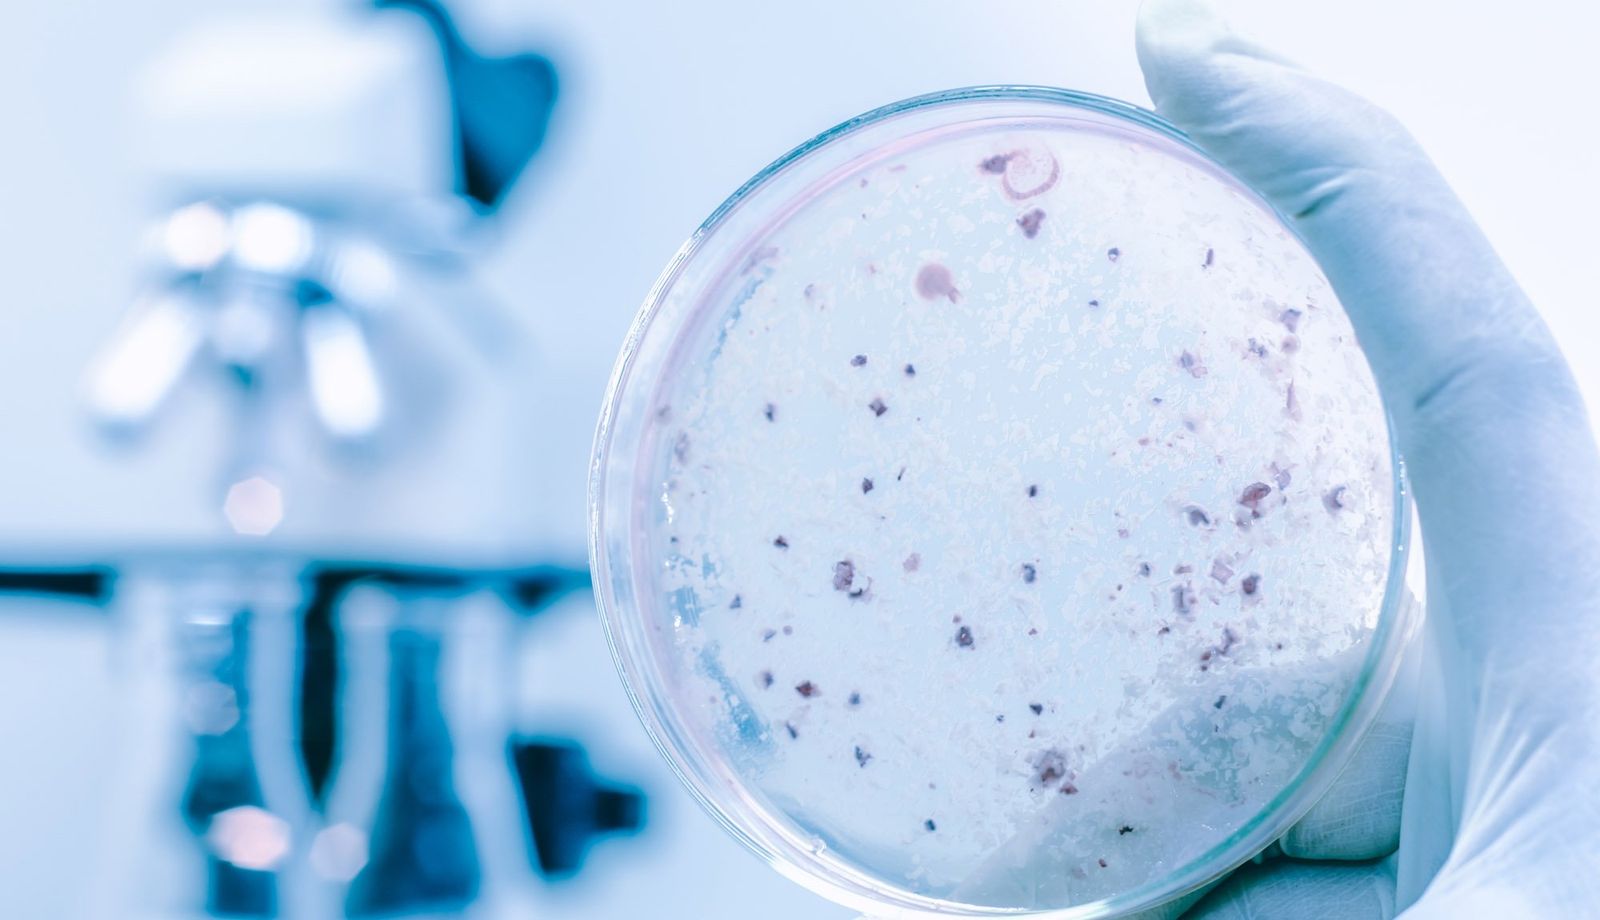

Health and Safety at Work Act 1974, COSHH Regulations, HSE L8 Guidance





Legionella Risk Awareness
Discover how Legionella bacteria grow in water systems, associated health risks, and control measures to prevent outbreaks.
Why This Course Matters
Legionella can be fatal — awareness is the first step toward prevention.
Legionella bacteria can lead to Legionnaires’ disease — a severe, sometimes fatal form of pneumonia. This disease is most commonly contracted by inhaling tiny water droplets from contaminated sources such as air conditioning systems, taps, or showers. Beyond the serious health implications, failure to control Legionella risks can result in legal prosecution and heavy fines. UK legislation requires employers, landlords, and duty holders to identify and control these risks. This course ensures your workforce understands the basics of Legionella risk and contributes to a compliant, safe workplace.
About the Course
This concise, video-based e-learning course is designed for all staff, regardless of role. It is accessible on desktop, tablet, or mobile devices and includes a brief assessment to test understanding. Learners can pause and resume at any time, and upon completion, receive an instant downloadable certificate — making it easy to track compliance.
Raise Awareness, Reduce Risk — Train Your Team in Minutes
This short course helps your team understand legal duties and prevention techniques, with zero disruption to operations.
What You’ll Learn
To make your learning experience as effective as possible, we’ve carefully structured each course into bite-sized modules. You’ll see a clear overview of every module, including its duration and the key topics it addresses, so you can easily navigate your safety training journey.
Module 1: Introduction
⏱ Duration: 6 minutes 36 secondsWhat is Legionella?
How it spreads and who is most at risk
Real-world consequences of exposure
Module 2: Legislation and Your Responsibilities
⏱ Duration: 4 minutes 09 secondsHealth and Safety at Work Act 1974
COSHH Regulations and HSE guidance
Employer and employee responsibilities
Accordion Item Module 3: Risks and Record Keeping
⏱ Duration: 4 minutes 17 secondsIdentifying high-risk areas and water systems
Monitoring water temperatures
Keeping accurate records and reporting requirements
Module 4: Controlling Legionella
⏱ Duration: 5 minutes 29 secondsPreventative measures for everyday settings
Flushing systems and maintaining water hygiene
Reducing stagnation and bacterial growth
Assessment and Certification
Multi-choice questionnareAfter completing each module in a course, learners will be prompted to take a short quiz to verify understanding. Upon successful completion of all modules, participants will receive a PDF certificate, ideal for training records and workplace audits.
Who Should Attend?
Designed for Every Industry, Every Role
General Employees and Office Staff
Understand how everyday environments may contribute to Legionella risks.
Maintenance and Facilities Personnel
Learn to identify, monitor, and reduce Legionella risks in water systems.
Health & Safety Supervisors
Reinforce legal duties and workplace policies regarding Legionella control.
Anyone Working Near Water Systems
Be aware of hidden risks in hot and cold water systems, cooling towers, and more.
Testimonials
See what our customers are saying about us
The email reminders that help people remain compliant save valuable time for everyone. The support we have received has been second to none – truly impressive.
As a company we have really benefitted from the compliance element of our user portal. The ability to quickly check if someone attending site is inducted and certified to complete the work is invaluable.
We’d like to sincerely thank PowerPlus for their support throughout the creation of our Contractor Approval Process on our portal – it has been truly invaluable.
Other Courses
If you like our Legionella Risk Awareness course, then here are a selection of courses we thing you’ll love




